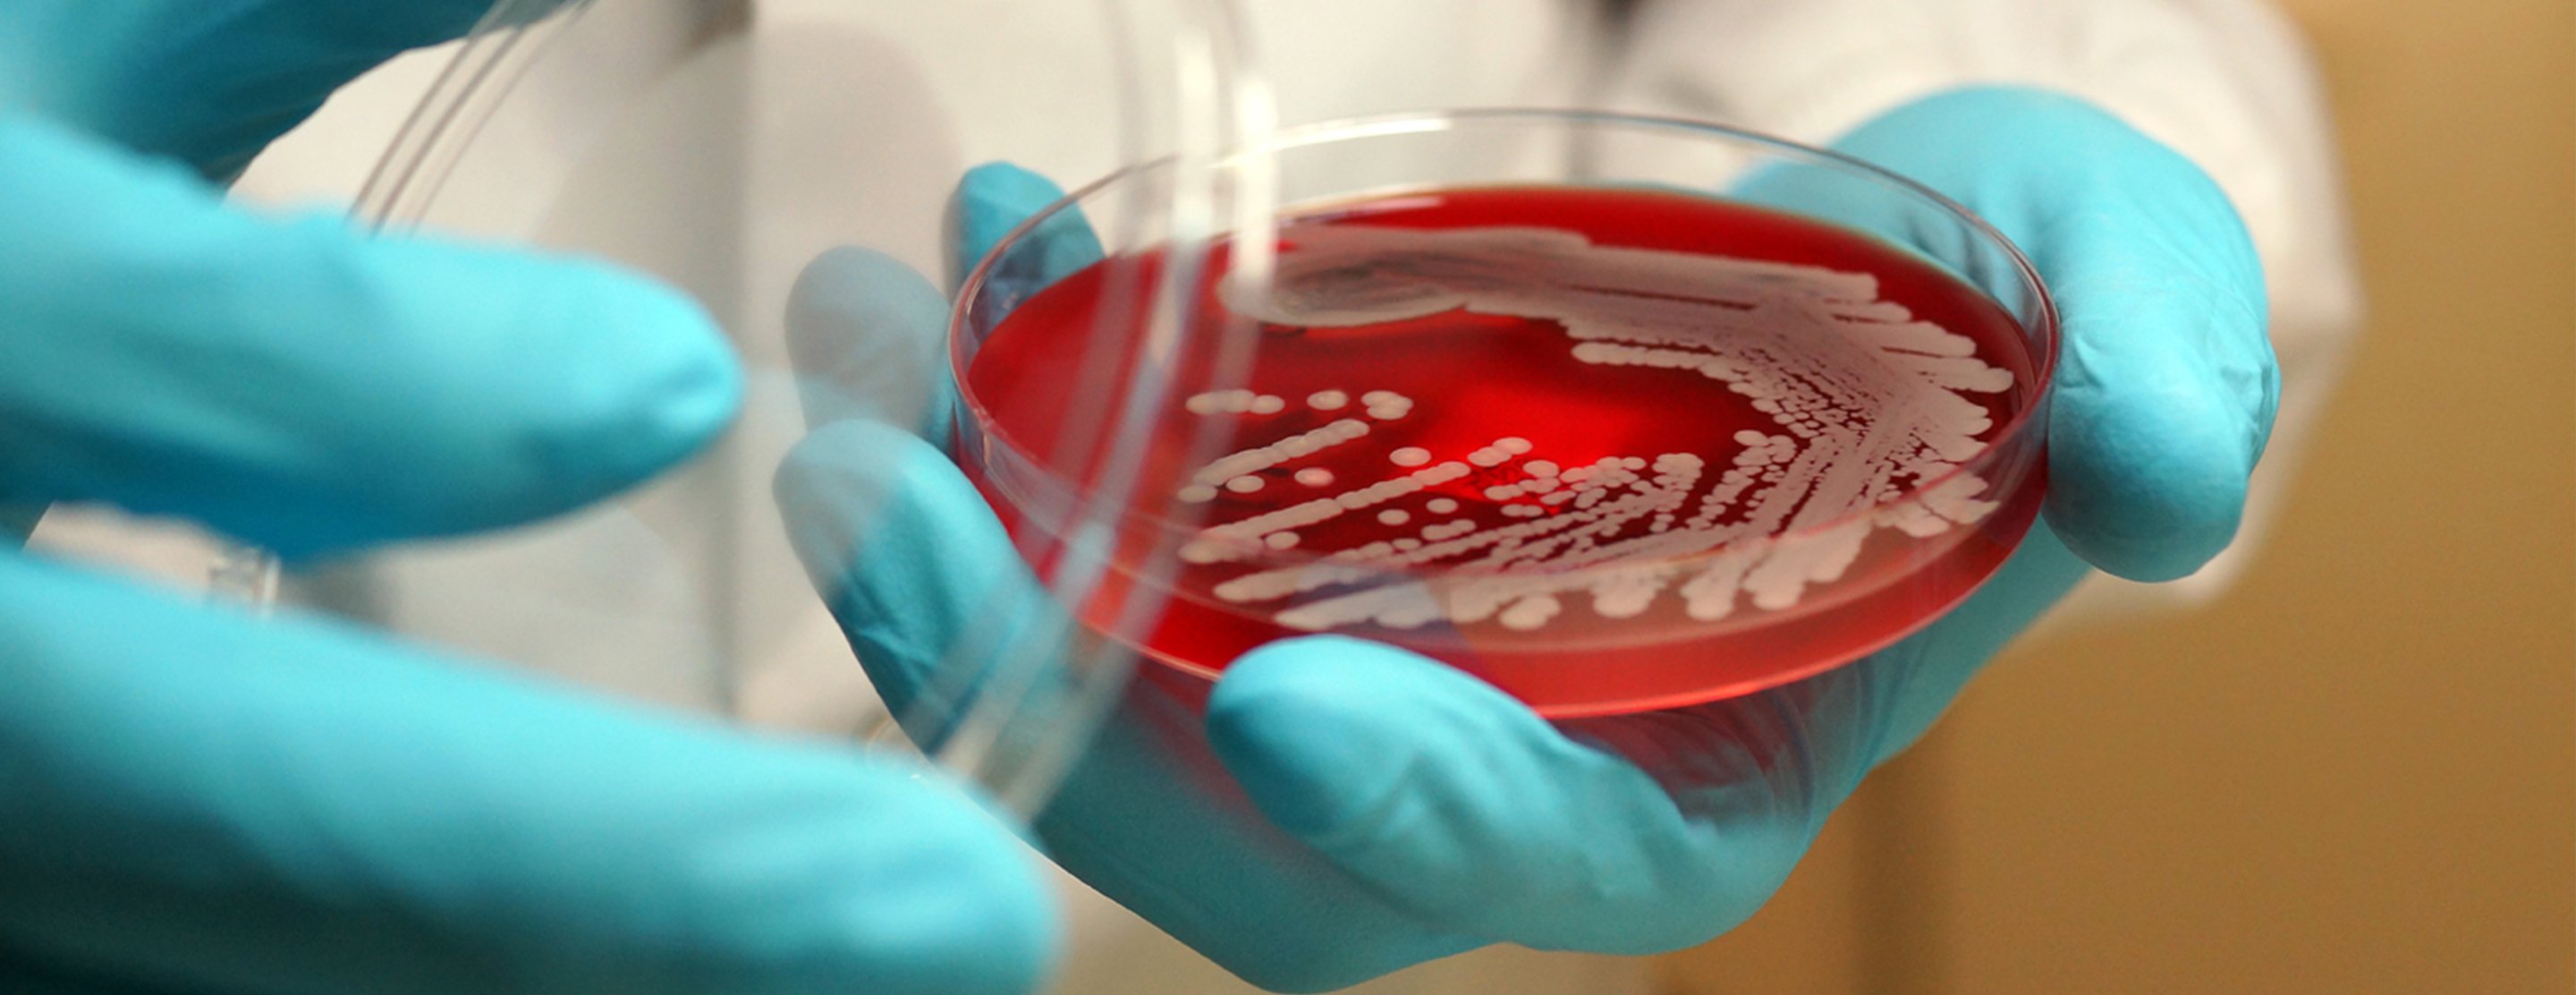

Aerobic bacteria
Definition
Aerobic bacteria are bacteria that can grow and live when oxygen is present.
References
Scheld WM, Patel R. Introduction to microbial disease: pathophysiology and diagnostics. In: Goldman L, Schafer AI, eds. Goldman-Cecil Medicine. 26th ed. Philadelphia, PA: Elsevier; 2020:chap 261.
Taber's Cyclopedic Medical Dictionary. 24th ed. F.A. Davis Company; 2021.
Review Date: 04/27/2023
The information provided herein should not be used during any medical emergency or for the diagnosis or treatment of any medical condition. A licensed physician should be consulted for diagnosis and treatment of any and all medical conditions. Call 911 for all medical emergencies. Links to other sites are provided for information only -- they do not constitute endorsements of those other sites. Copyright ©2019 A.D.A.M., Inc., as modified by University of California San Francisco. Any duplication or distribution of the information contained herein is strictly prohibited.
Information developed by A.D.A.M., Inc. regarding tests and test results may not directly correspond with information provided by UCSF Health. Please discuss with your doctor any questions or concerns you may have.